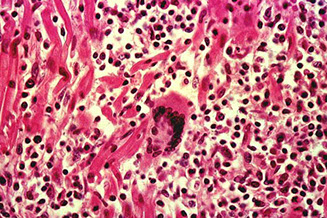

Heart
Cardiac Anatomy + Histiology
Cardiac Embryology
Cardiac Pathology
Cardiac defects, genetic
Valvular heart disease
Bicuspid aortic valve
Brugada syndrome
Non-cyanotic heart disease
- ASD, VSD, PDA, AV defects
Obstructive defects
Atherosclerotic plaques
Myocardial infarction (MI)
Dilated cardiomyopathy
- Chagas disease
Arrhythmogenic RV dysplasia
Hypertrophic cardiomyopathy
Restrictive cardiomyopathy
Takotsubo cardiomyopathy
Rheumatic valve disease
Acute Rheumatic heart disease
Chronic Rheumatic Heart Disease
Mitral valve prolapse
Pericarditis
Bacterial endocarditis
Nonbacterial thrombotic endocarditis
Libman-Sacks endocarditis
Myocarditis
Giant cell myocarditis
Hypersensitivity myocarditis
Cardiac amyloid
Cardiac sarcoidosis
Fabry's disease
Rheumatic carditis
Transplant
- Hyperacute rejection
- Acute rejection
- Acute antibody mediated rejection
- Cardiac Allograft Vasculopathy (CAV)
Myxoma
Rhabdomyoma
Papillary Fibroelastoma (PFE)
Cardiac fibroma
Malignant mesothelioma
Intimal sarcoma
Cardiac Anatomy + Histiology
Heart reaches maximum weight at 20 yo, and is usually 0.45% of Total Body Weight for males (~300 g) and 0.40% for females (~250 g), but is variable depending on age, and physical activity status also
Pericardium
Pericardium covers entire heart and extends a little bit over nearby vessels
Parietal pericardium is dense fibrous tissue that does not stretch, which is why you can get tamponade c a quarter liter of fluid
- has a thin layer of mesothelial cells on inner surface
- visceral peritoneum also has layer of mesothelial cells, and is separated from parietal pericardium c ~50 mL straw-colored fluid
- left atrium and mitral valve can be accessed from the transverse sinus
- fibrosis and chronic inflam can cause constrictive pericarditis (should r/o infective processes)
Cardiac skeleton at base of heart anchors the AV and aortic valves; whereas the conus ligament anchors, which are made of dense collagenous CT c elastic fibers and sometimes some fat mixed in
- mitral and aortic valves have more fibrous tissue than the right-sided (tricuspid and pulmonary)
3 layers of the heart in all areas: external epicardium, central muscular portion, and endocardium
- may correspond to the adventitia, smooth muscle media, and the tunica intima, respectively, of blood vessels in rest of body
- Endocardium - single layer of endothelial cells, right underneath which is loose elastic framework and collagen bundles, nerves and little blood vessels
- smooth muscle found beneath endocardium in artia and ventricles
Interatrial septum separates R from L atria
- up to 1/3 of adults have small patent foramen ovale, which has no clinical significance, but is usually closed by the fossa ovalis which is as thin as paper
Right atrium found on right lateral cardiac border
- right atrial appendage comes out anteriomedially over RA and covers the aortic root a bit
- Chiari's network is a net-like structure in right atrium near opening of IVC and coronary sinus and is remant of right sinus venosus valve; may be confused c rt atrial pathologies; but may protect from pulmonary embolisms, but may also cause PEs if broken off, and can help in formation of WPW syndrome [1]
- found in 2-14% of population


Cardiac Embryology
Oxygenated blood comes in through umbilical vein, and goes through a shunt in the ductus venosus away from liver towards the heart
- oxygenated blood entering from the inf vena cava mixes with somewhat less oxygenated blood from sup vena cava, which then goes through the foramen ovale from the right to the left atrium
- blood not going through the foramen ovale goes through RV to the pulmonary artery, where the ductus arteriosus connects the pulmonary artery to the aorta to shunt blood away from the heart
Blood returning from the hypogastric arteries around the bladder enter the umbilical

fetal circulation (from Wikipedia)
Cardiac Pathology
Cardiac defects, genetic
- single gene mutations (NKX2-5 [5q34], GATA-4 [8p], TBX-5 [12q], TBX-1 [22q], PTPN11, JAG1);
- structural chromosomal disorders (Trisomy 21 Down syndrome, 45 X Turner syndrome, 22q11 microdeletion DiGeorge syndrome, 7q11.23 microdeletion William syndrome);
- many are multifactorial
NKX2-5 - [5q34] encodes transcription factor expressed very early in cardiogenesis and is responsible for activating transcription of most genes involved in the process
- can have large variety of structural malformations
GATA-4 - [8p], encodes transcription factor important in embryogenesis; assoc c inherited septal defects, esp ostium secundum atrial septal defects
Holt-Oram syndrome (heart-hand syndrome)
AD, TBX-5 [12q]
- characteristic heart and upper limb abnormalities
- upper limb malformations may involve the radius, thumb phalanges, or carpal bones and they range from severe (phocomelia) to minimal (subtle carpal bone deformities)
- usually bilateral and symmetrical and if asymmetrical the left is more severely affected
- Cardiac malformations most commonly take the form of septal defects, especially secundum atrial septal or muscular ventricular septal defects
Noonan syndrome
AD, mutated protein tyrosine phosphatase, non-receptor type 11 (PTPN11) gene (same as LEOPARD syndrome and some cases of Juvenile Myelomonocytic Leukemia [JMML]); incidence in general population ~1/1,500, though the incidence in kiddos c congenital heart dz as high as 1/100
- right-sided heart defects including pulmonic stenosis and hypertrophic cardiomyopathy
- lymphatic malformations also common
- aka "the male version of Turner's syndrome"
- prolonged coag times (eg vWD phenotypes, factor V def, factor VIII def)
Down syndrome (Trisomy 21)
50% of cases with structural cardiac anomalies, classically an endocardial cushion malformation causing a membranous ventricular septal defect
- can also get patent ductus arteriosus, atrial septal defect and AV septal defects
Turner's syndrome
45 XO, neck webbing, cardiac anomalies in 1/2 of cases, bicuspid aortic valve is MC defect, then coarctation of the aorta. Aortic root dilation is common and may lead to aortic dissection
assoc c ganglioneuromas and gonadoblastomas
DiGeorge syndrome
- aka velocardiofacial syndrome, or Shprintzen syndrome
22q11 microdeletion, TBX1 gene. 75% c cardiac abnormalities, esp conotruncal malformations including tratralogy of Fallot, interrupted aortic arch, ventricular septal defects and truncus arteriosis
William syndrome
elastin gene, 7q11.23 microdeletion
- dysmorphic facial features, MR, short stature, hypercalcemia, abnormalities of CT (hernias, diverticula, joint laxity, skin laxity) and structural cardiac and vascular defects
- most distictive cardiac anomaly is supravalvar aortic stenosis (hourglass stenosis)
The vast majority of structural cardiac anomalies are "multifactorial" in origin. That is, while a Mendelian pattern of inheritance is inapparent and a specific genetic defect has not been found, there is a clustering within families and around particular exposures. Furthermore, it is known that offspring of consanguineous parents are strongly predisposed to "multifactorial" structural cardiac anomalies. Structural cardiac anomalies are prominent among the multifactorial disorders, others being pyloric stenosis, cleft lip and cleft palate
Valvular heart disease
zona fibrosa: inner and outer fibrous layer
zona spongiosa: middle layer with thin connective tissue
Bicuspid aortic valve
leaflets usually of unequal size
- calcific aortic stenosis
Complications: infectious endocarditis (10-40%); aortic dissection (1-2%)
- congenital bicuspid valves have a concomitant ascending aortopathy that puts them at inc risk for aneurysms and dissections of the ascending aorta
Brugada syndrome
Most prevalent in southeast Asia
- presents in healthy young men as sudden death during sleep
- has characteristic ECG pattern
- Mutations in 8 genes (SCN5A, GPD1L, CACNA1C, CACNB2, SCN1B, KCNE3, SCN3B, HCN4)
Non-cyanotic heart disease
left to right shunts (ASD, VSD, PDA, AV defects)
- ASD: secundum defects are the most common - occur in the region of the foramen ovale (LA --> RA), but can occur anywhere; usually asymptomatic initially; can get a paradoxical embolism
- VSD: opening in septum (LV --> RV); MC (75%) membranous (bc last area to form); VSD is the MCC congenital defect and occur in isolation > 1/3 of the time; small defects may close spontaneously, but larger defects could lead to a R-->L shunt
- PDA: PA connects to aorta in the fetus; normally closes with inc O2 tension, dec vasc resistance, dec PGE2 about 1-2 days after birth (but may be delayed with hypoxia, prematurity, or heart disease; causes L-->R vol and pressure overload; clinically will hear a machine murmur
AV defects: endocardial cushion defect results from absence of septum and AV valves, physiologically mimicking ASD; assoc c Trisomy 21
Obstructive defects (Coarctation)
Narrowing of the aorta distal to the ductus; isolated in 1/2 of cases; lesions vary in length; assoc c fibroelastosis, PDA, VSD, bicuspid AV, TGA; BP elevated in arms (BP arms > legs); assoc c Turner's syndrome and bicuspid aortic valves
Pre-ductal: usually detected in infancy
- heart failure, weak pulses and cyanosis of lower extremities, assoc c Turner syndrome
Post-ductal: usually present in older children or adults
- Hypertension in upper extremities; hypotension in lower extremities
Cyanotic heart disease: right to left shunts (TOF, TGA, truncus arteriosus)
Tetralogy of Fallot
MCC cyanotic congenital heart dz, large VSD, overriding aorta, RV outflow tract obstruction (pulmonary stenosis/atresia), RV hypertrophy; inc PAP causes R-->L shunt
- majority of blood bypasses lungs --> hypoxia and cyanosis
- Tet spells: squatting to change shunt direction
Px: long-term survival rates with surgical repair
- TGA: 2 types; abnormal development of truncus arteriosus; aorta arises from the RV and pulmonary artery arises from the LV; incompatible with life without a connection (foramen ovale and ductus arteriosus); can be surgically repaired
Atherosclerotic plaques
Endothelial cell dysfunction --> macrophage and LDL accumulation --> foam cells --> fatty streaks --> sm muscle migration (PDGF and TGF-B) --> fibroatheroma (fibrous plaque) --> complicated fibroatheromas (hemorrhage and thrombosis)
Abdominal aorta > coronary arteries > popliteal > carotid artery
- spares upper extremities, aortic arch, mesenteric arteries
Patchy intimal thickening and secondary medial degen lead to weakening of vessel wall and narrowing of lumen
- complicated by aneurisms, ischemia, infarct, thrombi / emboli
Sx: angina, claudication
Vessel anatomy: made of adventitia, media, intima
- primary lesion in the intima (lipid core and fibrous cap), medial changes are secondary (loss of elastic fibers)
Osler's sign: pseudoHTN from atherosclerotic hardening of vessels that falsely elevates BP readings
- if pulse is felt after cuff inflated above systolic BP, it may indicate pseudoHTN (Osler's maneuver)
Myocardial infarction (MI)
defined area of necrosis >1 cm due to ischemia
Subendocardial: <1/3-1/2 myocardial thickness (<50%)
- subendocardium esp vulnerable to ischemia 2/2 few collaterals, inc pressure
- see ST depression on EKG (NSTEMI)
Transmural: total occlusion causes lots of necrosis of the entire wall
- Q waves and ST elevation on EKG (STEMI)
MI's grossly:
<2 days - brown and hard to see; can use nitroblue tetrazolium to help visualize (LDH allows nitroblue tetrazolium to stain normal muscle, but not dead muscle)
2-4 days: yellow necrotic zone surrounded by hyperemic zone
Later infarcts: gelatinous granulation tissue progressing to scar
Know sequence of changes in MI... (206-208)
Reperfusion - may result from balloon angioplasty or thrombolytic therapy
- accelerates the aging of the infarct, more hemorrhage with infarct and more contraction band necrosis
MI complications / healing:
Cardiac arrhythmia: important cause of death before reaching hospital
- common in the first few days
LV failure and pulmonary edema
Cardiogenic shock
- heart fails to generate output to perfuse tissues (dec SV, inc EDV, inc ESV, HypOtn, inc HR, JVD, pulmonary edema, clammy skin, weak pulses)
- labs: met acidosis, inc lactic acid, inc BUN/creatinine, PCWP >15, dec cardiac index
- tx: IV fluids CONTRAindicated (if fluids indicated do 250 mL trials), give Dopamine, dobutamine, avoid B-blockers and negative inotropes, IABP can help to rapidly stabilize
3-5 days: postinfarct fibrinous pericarditis (friction rub for 3-5 days)
- relieved by leaning forward
In normal healing, would grossly see soft, yellow-tan tissue c hyperemic border
- micro: dead myofibers and neutros c infiltrating macros at the edge cleaning up house
4-7 days post MI: ventricular free wall rupture --> cardiac tamponade; rupture of papillary muscle --> severe mitral regurg; intraventricular septum rupture --> VSD
several weeks: Dressler's syndrome - caused by production of Ab's against ag's released by heart in MI (Tx: NSAIDS)
Months / years later: aneurism formation --> dec CO, arrhythmias, emboli from mural thrombus

Holt-Oram

Noonan

DiGeorge Syndrome


Brugada Syndrome

Coarctation of the aorta




Dilated cardiomyopathy
MCC cardiomyopathy (90%); MCC heart transplantation; 3rd MCC heart failure [2]
Progressive cardiac hypertrophy, dilation, systolic dysfunction
- laterally displaced apical impulse, narrow pulse pressure, bundle branch blocks (cause arrhythmias that lead to edema and pleural effusions)
Etiology: 1/3 genetic (X-linked dilated cardiomyopathy assoc c mutation of dystrophin gene, the same as implicated in Duchenne and Becker muscular dystrophy
- AD dilated cardiomyopathy assoc c large number of mutations, MC in MYH7 gene encoding B myosin heavy chain
***ABCD*** --> chronic Alcoholics, BeriBeri, Coxsackie B virus, Cocaine (Chronically), Chagas, Doxorubicin (adriamycin), and postpartum
-Adriamycin: 1.7% toxicity incidence, grading based on sarcotubular dilatation (vacuolization) and myofibrillar loss: process all for EM
Gross: enlarged, flabbly heart, over 900 g, all 4 chambers dilated, ventricles > atria
- explains the systolic dysfunction, with a failing EF (<40%), S3
Imaging: Balloon-heart on cxr
Micro: nonspecific, myocyte hypertrophy, interstitial fibrosis, wavy fiber change or myofiber loss, scanty mononuclear inflam infiltrate
- Eccentric hypertrophy (sarcomeres added in series) --> vol overload
Chagas disease
Micro: Dense inflam c myocyte necrosis and trypanosome amastigotes in myocytes (seen in acute dz)
Arrhythmogenic RV dysplasia (AVRD; Uhl anomaly)
- aka AVR Cardiomyopathy (AVRC)
Uncommon, familial (AD) form that affects young adults causing sudden death, fatty replacement of RV
Genetics: Ryanodine receptor, plakoglobin, desmoplakin, desmin
- some even more rare versions exist
--- Naxos disease: palmiplantar keratoderma and wooly hair
--- Carvajal syndrome: LV cardiomyopathy
Imaging: MRI shows thinned ventricle, dec EF, fat replacement
Micro: RV markedly thinned and replaced by fat
- DM and roid use also assoc c fatty replacement, but not arrhythmias or cardiomyopathy
Px: may be attributed to 3% of sudden cardiac deaths in the US
Long QT syndromes (LQTS)
Prolonged QT interval prediscposes to ventricular arrhythmia
- QT interval influenced by both acquired and genetic factors
- despite autosomal inheritance, 2:1 female predominance; bc has greater penetrance in females
- genetic factors now categorized by genotype (LQTS1 to LQTS7)
LQT1 (KCNQ1) - 11p15.5, encodes a portion of a voltage gated potassium channel, MC mutated gene in LQT syndrome
- exercise (esp swimming) triggered arrhythmias
LQT2 (KCNH2, HERG) - 7q35-36, encodes a second voltage activated potassium channel; 2nd MCC LQTS
- auditory stimulus or emotional stimulus triggered arrhythmia
LQT3 (SCN5A) - 3p21-25, sleep triggered arrhythmias
LQT7 (KCNJ2) - Encodes portions of a channel shared c skeletal muscle; mutations cause Andersen-Tawil syndrome (triad of episodic paralysis, long QT interval, and dysmorphic features)
Hypertrophic cardiomyopathy
- aka idiopathic hypertrophic subaortic stenosis
Septal hypertrophy (seen in 90%) which causes outflow obstruction bc gets all up in the mitral valve's grill
- up to 1 in 500 incidence
Sx: sudden death c exercise in young athletes
- - inc septal size can outgrow the blood supply and cause asymptommatic subendocardial micro-infarcts that also cause arrhythmias from conduction probs created by fibrous scars
PE findings: Murmur inc c sudden standing and valsalva (murmur inc c inc LV vol)
- Bisfriens carotid pulse: brisk rise, then decline, then 2nd rise
1) large a wave, 2) palpable S4 gallop, 3) Brisk, bifid carotid upstrokes c spike and dome contour
Imaging: septum >1.3x left ventricle on echo
Genetics: defective B myosin heavy chain gene (MYH7 gene, MC mutation is R403Q) on chr 14 (50%), AD inheritance
- assoc c Fiedrich's ataxia
Micro: myofiber disarray and entanglement (non-specific, also seen in nl heart bwt ventricle and septum)
- thick mitral valve, large left atrium and small left ventricle
Asymetric hypertrophy (sarcomeres added in parallel) of septum
Dx: ECG will find LVH; catheterization finds Brackenbough sign (dec PP c extra beat in systole)
Tx: B-blocker (dec AV node velocity, thus dec risk fatal arrhythmia) or non-dihydropyridine Ca2+ channel blockers
- must Avoid ACE-I and vasodilators (cause inc LVOT from dec vol)
- pt must avoid strenuous exercise
- may consider alcohol septal ablation or surgical myotomy
--- alcohol septal ablation: causes triphasic response: 1) acute dec, 2) partial, 50% inc, 3) dec over months to years later
-- surgical myectomy causes long-term improvement in over 90% pts
Restrictive cardiomyopathy
Causes: Sarcoidosis, Amyloidosis, Hemochromatosis, Cancer, Fibrosis (endocardioelastofibrosis [thick fibroelastic tissue in endocardium of kiddos]), Loffler's syndrome (endocardial fibrosis c eos [NOT Loffler's eosinophilic pneumonitis, which is assoc c ascaris])
Primary decrease in ventricular compliance, resulting in impaired cardiac output
- basically, a bunch of junk is deposited in the myocardium, which stiffens the heart and doesn't allow it to fill properly (dec diastolic filling), though it is still able to squeeze out whatever blood it gets (normal to inc EF)
Endocardioelastofibrosis - common cause worldwide, 10% of childhood heart dz in tropical regions
Imaging: EKG shows low voltage, ST-T wave changes
Gross: varies depending on cause, atrial dilation (bilateral), endocardium thickened and opaque (white), valvular thickening, mural thrombi may be present
Micro: dense endocardial fibrosis, extending into subendocardial myocardium
Takotsubo cardiomyopathy
- aka transient apical ballooning syndrome
Caused by intense emotional stress, such as the death of a loved one, which is why it may also be called "broken heart syndrome"
- can lead to acute heart failure, arrhythmias, and ventricular rupture
- catecholamine-induced transient myocardial stunning
Rheumatic valve disease
multisystem inflammatory disease following group A streptococcal pharyngitis, occuring 1-4 weaks post-infection
- type II HS 2/2 ab's against M-protein (not a direct result of bacterial toxin)
*** Assoc c A's *** A-group strep phAryngitis, Aschoff bodies, Anitschkow's cells, ASO titers, Ab's to M protein (type II HS)
- 3% of patients with group A streptococcal pharyngitis
All 4 valves (MV > AV > TV >> PV); high-pressure valves are most affected
Zona spongiosis obliterated by fibrosis and neovascularization , no myxoid substance
Micro: Aschoff bodies (granulomas c giant cells), Anitschkow's cells (activated histiocytes c rod-shaped catepillar nucleus)
Dx: Major (JONES) criteria:
Joints
O - pancarditis (tx: ASA)
Nodules (subcutaneous)
Erythema marginatum (macular rash starting on trunk and arms)
Sydenham's chorea
minor criteria: fever, arthralgia, inc CRP/ESR, EKG changes
Tx: PCN or erythromycin for strep pharyngitis prevents progression to acute rheumatic fever
- acute rheumatic fever: NSAIDS, PCN / erythromycin (to eliminate strep sources, even if pharyngitis resolved)
-- follow CRP + ESR to monitor progression
-- ASA for carditis
Acute Rheumatic heart disease
Endocarditis: small excrescences along line of valve closure
Myocardium: Aschoff bodies (groups of big macrophages c lymphos and plasma cells)
Pericardium: Fibrinous pericarditis
McCallums patch: inflammation of endocardium in acute rheumatic heart disease, can see underlying myocardium
Chronic rheumatic heart disease
- Latent period of 20-30 years before symptoms appear
- Commissural fusion, cusp fibrosis, retraction, calcification
- Shortening and thickening of chordae
Mitral valve prolapse (MVP)
- 5% of adult population, ages 20-40, women > men
- mitral valve cusps are soft, large and balloon into left atrium during systole
- expansion of zona spongiosa of myxoid connective tissue




Dilated Cardiomyopathy

Arrhythmogenic right ventricular cardiomyopathy (ARVC), biventricular, autopsy heart in a young man who died suddenly playing basketball. Top left demonstrates increased fat in the outer walls of the right ventricle and left ventricular posterolateral walls. A higher magnification of the right ventricle is seen at the top right image; the anterior wall is nearly completely replaced with fat, and fibrofatty irregular posterior wall involvement is seen. Note that no actual thinning of the wall itself exists, although the muscular portion is in some areas completely missing. The bottom left image demonstrates a full thickness of the right ventricle stained with Masson trichrome. The residual muscle is present only in a bandlike area of scarring, and subepicardial scarring is present as well. The characteristic myocyte vacuolization, depicted in the bottom right image, is seen in nearly all areas of ARVC within the scarred areas

Hypertrophic (Obstructive) Cardiomyopathy



Restrictive Cardiomyopathy


Tako-tsubo dz - Apical ballooning (left) with tako-tsubo japanese octopus trap (right)


Aschoff body with "caterpillar" nuclei

Rheumatic Heart Dx (RHD), Infectious Endocarditis (IE), Marantic Endocarditis (Non-bacterial thrombotic endocarditis; NTBE), Liebman-Sacks Endocarditis (LSE)

Normal mitral valve (left) and Rhuematic Mitral Valve (with stenosis; right)`

Aschoff cell


MCCallum's patch - Gross finding of endocardiual thickening in post wall of LA 2/2 inflam and 'jet'-trauma


Chronic Rheumatic Heart Disease
MVP with regurgitation

Pericarditis
Classic sx: 1) precordial chest pain relieved by leaning forward, worse when leaning back; 2) pericardial friction rub, 3) Diffuse ST elevation and electrical alternans
- also have distant heart sounds and pulsus paradoxus
-- pulsus paradoxus: fluid in pericardial sac compresses the flimsy RV, hindering RV expansion, inc RV pressure displaces septum to the left, dec LV vol, dec LV SV, dec systolic BP (worsened by inspiration)
Acute fibrinous pericarditis: 2-5 days s/p transmural infarct caused by underlying inflam
- get the classic sx of pericarditis, and PR-depression (pathognomonic)
Ewart's sign: dullness over left posterior lung field 2/2 compression atelectasis from pericardial effusion
Different flavors: serous (assoc c SLE, RA, viruses), fibrinous (MI, rheumatic fever), hemorrhage (TB, cancer), purulent
Tx: NSAIDS (may do nothing...?), colchicine (if recurrent), avoid anticoagulants, drain the fluid yo
Bacterial endocarditis
*** FROM JANE*** Fever, Roth's spots, Osler's nodules, new Murmur, Janeway lesions, Anemia, splinter hemorrhages on Nail bed, Emboli
Mitral valve MC involved
Acute: assoc c S aureus
- large vegetations on previously normal valves; rapid onset and often fatal despite tx
Subacute: Strep viridans
- smaller vegetations on valves c previous damage caused by dental procedures; insidious onset
Associations to make with IE
S aureus: IVDA
S epidermidis: prosthetic valves
S viridans: sub acute
Enterococci: normal or damaged valves
S bovis = S gallolyticus: colon CA
Pneumococcus: alcoholics
Gram negative: IVDA, DM, immunocompromised
Fungal: IVDA, immunocompromised
Culture is negative in 5-10% of endocarditis, think HACEK or mycobacteria (fastidious organisms), or Rickettsia, Q-fever, Whipple's (intracellular bugs)
- HACEK = Hemophilus, Actinobacillus, Cardiobacterium, Eikenella, Kingella
2009 endocarditis prophylaxis:
1) congenital cyanotic lesions (not ASD or VSD)
2) prior valve repair c synthetic material (no tx for MVP)
3) prior hx of endocarditis
4) hx of heart transplant
Nonbacterial thrombotic (Marantic) endocarditis
Hypercoagulable states or DIC in 1/2 from antiphospholipid syndrome, deposition of fibrin + platelets on leaflets of cardiac valves, thrombus on surface, no bugs and few inflam cells
- may be the result of an indwelling catheter
Gross: small nodules on lines of closure
- may be confused c IE
Micro: fibrin and platelets, without significant inflammation
Libman-Sacks endocarditis
Assoc c Systemic Lupus Erythematosus
-- most often b9; may be assoc c mitral regurgitation or mitral stenosis
- can also occur with Marfan's syndrome (aortic dissection)
Gross: Warty vegetations covering both sides of valve surfaces
- fibrinoid necrosis and inflammation
***SLE causes LSE ***
Tx: anticoagulants and tx SLE
Myocarditis
inflammation resulting in injury to cardiac myocytes (necrosis and/or degeneration) not typical of IHD, infections (MCC is VIRAL, Coxsackie A + B, enteroviruses, cytomegaloviruses, HIV, Chagas, toxoplasmosis, trichinosis, Lyme disease, diphtheria), cardiac allograft rejection, collagen vascular diseases, drug hypersensitivity, sarcoidosis
symptoms: asymptomatic, congestive failure, arrhythmias, self-limited
morphology (Gross): cardiac dilation, myocardium flabby, pale, focal hemorrhage
- microscopic-
acute viral: lymphos and other mononuclear cells, myocyte degeneration and/or necrosis, may see viral inclusions
parasitic: see bugs, and eos
bacterial: neutros
Giant cell myocarditis
An emergency! "Fielder's" myocarditis, aggressive, rapidly progressing dz of young white adults that present c congestive heart failure
- is an indication for transplant
Micro: MNGCs, CD8 lymphos, eos and diffuse necrosis
DDx: sarcoid, hypersensitivity
Px: 6 month survival; can recur in heart transplants
Hypersensitivity myocarditis
interstitial infiltrate of macros and eos assoc c meds
- linked to a variety of medications, esp methyldopa
- MC in pts undergoing heart transplant, possible link to pre-transplant drug regime
Micro: Little to no necrosis, no granulomas (may have multinucleated cells), few sx
Cardiac amyloid
Rare (~4/1M), a restrictive cardiomyopathy, caused by extracellular deposits of insoluble autologous proteins, ~95% misfolded B-pleated sheats and 5% of chaperone "P" (pentameric) proteins
- >30 types of amyloid fibrils identified, can be either systemic or localized
- Gold standard is endomtocardial bx with polarized Congo red stain showing apple-green birefringence (just brightfield is not diagnostic); EM can also be used to confirm the dx
AL (light chains, plasma cell neoplasm), AA (chronic inflam diseases, rare in heart), ATTR (aka AS, transthyretin or prealbumin, senile amyloid)
- AL and ATTR comprise >95% of all cardiac amyloid
- AL assoc c plasma cell dz, and is aggressive c median survival of 4 months
- myocardial ischemia is an important complication of this disorder
- 10 nk non-branching extracellular fibrils: homogeneous waxy material present first around blood vessels, Congo red positive, apple green birefringence
EM: needed in Fabry's disease and adriomycin tox
Cardiac Sarcoidosis
Relatively rare, occurs in up to 10% of all pts c systemic sarcoidosis
- microscopically similar to sarcoid in other organ systems
Epithelioid granulomas and MNGCs
- Schaumann bodies: inclusion bodes in GCs made of calcified protein
- Asteroid bodies: stellate inclusions that stain for ubiquitin abs
Don't see many eos or neutros (vs GC myocarditis)
- CD4 lymphos should be present
No necrosis, but extensive myocardial fibrosis
Fabry's disease
x-linked recessive form of sphingolipidosis due to deficiency of a-galactosidase A
- Angiokeratomas, Renal insufficiency and Cardiac failure, peripheral neuropathy (Burning pain)
- histo: vacuolated myocytes
Genes: Xp22, GLA gene
EM: intralysosomal dense lamallae c concentric or packed arrangment (Zebra bodies)
Loeffler endomyocardial fibrosis (LEMF)
Rare, restrictive cardiomyopathy, unknown cause, where endomyocardium progressively replaced by fibrosis with eventual heart failure and poor px
Micro: usually eosinophilia
Rheumatic carditis
uncommon cause of myocarditis
- Aschoff nodule: fibrinoid necrosis of heart muscle
-- Anitschkow cell: histiocytes with condensed chromatin that looks like a catepillar)
-- Aschoff cells (MN giant cells, look like caterpillars)
-- Collagenolysis
- Pancarditis
Transplant
Hyperacute rejection
- occurs immediately to hours after transplant, resulting in graft failure; rare
- see hemorrhage, edema and platelet aggregates and later PMNs in blood vessels
- findings not specific bc not enough time to react
Acute Rejection
- lymphos, macros, eos, but no neutros or plasma cells
-- PMNs assoc c ischemia, Ab-mediated rejection, or infx
-- plasma cells assoc c Quilty lesion or PTLD (too short for plasmas)
Seeing eosinophils should make you think of toxoplasmosis, CMV or drug rxn
Acute antibody mediated rejection
Micro: capillary injury, endothelial swelling, intravascular macros, edema, hemorrhage, neutros near capillaries, thrombi and myocyte necrosis mediated by IgG, IgM, IgA, C3d, C4d, C1q
Acute cellular reaction, grading
Grade 1, mild - Interstitial and/or perivascular infiltrate with up to 1 focus of myocyte damage
- low probability of progression and probably does not need treatment
Grade 2, moderate - 2 or more foci of infiltrate with assoc myocyte damage
Grade 3, severe - Diffuse infiltrate with multifocal myocyte damage +/- edema/hemorrhage/vasculitis
Quilty lesions
also known as endocardial infiltrates, were first described by Billingham who gave them the surname of the patient first showing this lesion (1). Quilty lesions have been the subject of more than a dozen different studies, and there is still no consensus as to their etiology or significance. They have been associated with the use of cyclosporine and waxing and waning levels of immunosuppression (2-4). It has also been suggested that Quilty lesions represent a "benign" form of rejection (5), an analogue of vascular rejection (6, 7) or even incipient post-transplant lymphoproliferative disorder, the latter of which has been proven incorrect (8). More recent studies in experimental animals suggest that they may be sites of antigen processing and low grade immune stimulation (9). In human and experimental animals, Quilty lesion are comprised predominantly of T cells, with the CD4 subset predominating over CD8 cells by a ratio of 2-3:1.
: dense lymphocytes in endocardium in pts on cyclosporine
- not necessary to distinguish Quilty A and B lesions anymore
-- Acute rejection tends to spread a little bit deeper
- Quilty = B + T cells (rejection is usually only T cells)
-- core of B cells surrounded by T cells
- Quilty lesions usually do not persist, but may recur, and have no bearing on graft outcome
Cardiac Allograft Vasculopathy (CAV)
MCC death, long-term, in transplant pts
Micro: vessels show concentric intimal thickening, few calcifications
Usually becomes apparent 5 years post-transplant
Myxomas
MCC primary cardiac cancer in adults
-50% primary heart tumors; 75% in left atrium
- Soft, pale, lobulated, +/- hemorrhages/calcifications grossly
- attach to foramen ovale near septum
- Tumor makes lots of metalloproteinases --> lots of emboli
- May derive from multipotential mesenchymal cell - not certain
- calretinin positivity suggests neural derivation
Sx: Multiple sporadic syncopal episodes from "ball-valve" obstruction in LA near fossa ovalis
Micro: hypocellular c myxoid background
Round/polygonal/stellate cells in loose mucoid stroma
- can form solid cords w/ vasc channels
- do not find mitoses, pleomorphism, or necrosis
- also see surface thromboses, Gamna-Gandy bodies, ossification ("petrified" myxoma), cartilage, hematopoiesis, thymus/ foregut (which may account for mucin secretion)
-- myxomas may grossly be mistaken for an embolus, except for the fact that they are attached to heart by a stalk of tissue
IHC: (+) CD 31/34, calretinin (>75%), CEA, EMA, keratin (in glands)
- variable S100
DDx: cardiac calcified amorphous tumor ("cardiac CAT"), which is a pseudoneoplastic lesion caused by organization, degeneration, and calcification of a mural thrombus
Genetics: Sporadic (LA in middle aged women) and familial causes (LA in young men, + others [the Carney complex])
- mostly sporadic, some (~7%) assoc c Carney's complex, familial myxomatous syndrome, or TS complex
- also assoc c GNAS1 gene mutation in McCune-Albright
Carney complex: Cutaneous and cardiac myxomas (myxoid FAs); spotty skin pigmentation (lentiges and blue nevi), endocrine overactivity (adrenal, testicular, thyroid and pituitary)
***aka***
TAME: Testicular sertoli cell tumor, Adenomas (breast, pituitary, thyroid), (atrial, skin, breast) Myxoma, Ephelides
LAMB: Lentigines, Adrenocortical dz, Melanotic schwannoma, Blue nevi
- atrial myxomas assoc c Carney complex more common in RA
- Carney complex in young adult females (25 yo)
- has null mutations in PRKAR1A which encodes cAMP-dependent protein kinase
Tx: excision curative; recurrence rare (though more likely in familial form)
Rhabdomyomas
MCC primary cardiac tumor of infancy and childhood
- often multiple, and usually arise int he ventricles
Gross: solitary or multinodular yellow to gray nodules, up to 4 cm diameter, equal freq in both ventricles, less common in atria
Micro: eosinophilic, polygonal cells c large glycogen-rich cytoplasmic vacuoles c stranding "spider cells"
Genetics: may be isolated by >50% assoc c Tuberous Sclerosis
IHC: (+) Fli-1, CD31/34, HMB45 (variably)
- negative calertinin, S100
Tx: unless sx are severe, surgical excision may not be necessary, and they frequently undergo spontaneous regression
Px: Metastasis are 20-40x more common than primary cardiac tumors
Papillary Fibroelastoma (PFE)
MC (75%) cardiac valve tumor, 2nd MC primary cardiac tumor
Usually seen on the aortic valve [?]
Gross: Resemble Lambl excresences, except can be found on any valve whereas Lambl excresences found on aortic valve closures [?}
- for best viewing, try submerging underwater
Micro: fine, branching avascular papillae lined by endothelium
IHC: elastic stains highlight elastic parts of the papillae
Tx: surgery
Px: depends on tumor mobility, recurrence is rare, malignant transformation does not occur
- thrombus may form on the tumor and embolize
Cardiac Fibroma
2nd MC primary cardiac tumor in kiddos
B9 hamartomatous mesenchymal tumor
- occurs as a single lesion (vs rhabdomyoma) on ventricular septum
Assoc c Gorlin syndrome (nevoid basal cell carcinoma syndrome [NBCCS] in 1/20)
Gross: rubbery, white, well-circumscribed
- can be infiltrative
Micro: Uniform spindle cells amongst collagenous matrix
IHC: trichrome (stains collagen surrounding cells, (+) vimenting, smooth muscle actin
(-) desmin, MyoD1, S100, HMB45
Tx: Resection; can do transplant if unable to be resected
Px: no malignant transformation; good outcomes even c incomplete resection
Cardiac Angiosarcoma
asdf
Malignant mesothelioma
MC primary pericardial malignant tumor
- may be related to asbestos, not clear
IHC: (+) D240, WT-1, cytokeratins
- lymphatic tumors can also be D240 (+), but not cytokeratin (+)
Intimal sarcoma
MC primary cardiac sarcoma
IHC: (+) MDM2 (nuclear)
Gene: amplification of 12q13, the MDM2 gene locus
Pericarditis

Bacterial Endocarditis

Infective Endocarditis (IE)

Marantic endocarditis

Liebman-Sacks endocarditis


Gian cell myocarditis

Hypersensitivity myocarditis. In this explanted heart in a transplant recipient, there are scattered interstitial infiltrates, without myocyte damage. A. There is interstitial inflammation with eosinophils and mononuclear cells

Myocardium c pale pink material bwt myocardial fibers, characteristic for amyloid. Amyloid causes "infiltrative" or "restrictive" form of cardiomyopathy. Pts get arrhythmia during surgery




Fabry dz, EM

mixed mature of the inflammation and the prominence of eosinophils. Eosinophils are a common component of the inflammation associated with acute rejection early after transplantation in liver, lung, kidney and heart allografts

ISHLT Transplant Rejection Schema (2004)



This is a typical example of an endocardial infiltrate or Quilty lesion. Note the endocardial location of the inflammation, and smooth border with the underlying myocardium
Myxoma



Myxoma

Rhabdomyoma

Papillay Fibroelastoma


Cardiac fibroma in pt c Gorlin syndrome


Intimal sarcoma

References
1. AKM Monwarul Islam. Chiari network: A case report and brief overview. J Saudi Heart Assoc 2013 Jul; 25(3): 225-229
2. Maron, Barry J. Contemporary Definitions and classification of the cardiomyopathies: an American Heart Assciation Scientific Statement from the Council on Clinical Cardiology, Heart Failure and Transplantation Committee. Circulation. Apr 11 2006; 113(14):1807-16
